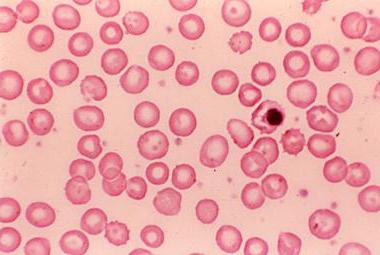
image

1483
27 Января 2017
Повышенное соэ у ребенка причины. Когда не стоит беспокоиться, а когда обратить внимание. Синдром повышенного СОЭ. Лечение.
При обращении в больницу с заболевшим ребенком или на обязательном медицинском осмотре родители нередко получают от врача (наряду с другими исследованиями) направление на общий анализ крови. По этому анализу выявляются различные показатели, среди которых СОЭ (скорость оседания эритроцитов) или РОЭ (реакция оседания эритроцитов). Этот показатель дает понять, с какой скоростью эритроциты (красные клетки крови) склеиваются друг с другом.
По повышенному значению СОЭ и другим признакам заболевания врач ставит диагноз.
Как сдавать анализ
Общий анализ крови — обязательное лабораторное исследование. Он показывает не только СОЭ. В ходе исследования определяются количество эритроцитов, тромбоцитов и лейкоцитов, уровень гемоглобина и гематокрит. Для того чтобы исследование было точным, больному ребенку следует подготовиться к сдаче крови. Главным условием является отказ от пищи минимум за 4 часа до сдачи биологического материала.
Для исследования подходит капиллярная и венозная кровь. В первом случае кровь берется из пальца (чаще всего левой руки). Предварительно кожу обрабатывают ваткой, смоченной спиртом. При помощи специальной иглы делают небольшой прокол (размером около 2 мм), после чего убирают первые капли крови. Затем при помощи специального переходника самотеком забирают кровь из пальца и переливают ее в пробирку.
Все используемые материалы и инструменты должны быть стерильными. Пробирки маркируются и отправляются в лабораторию. После манипуляции к пальцу прикладывают ватный шарик с антисептиком. Техника забора капиллярной крови для детей старше 1 года и взрослых одинакова.
Чтобы избежать ложноположительного результата (повышение СОЭ без наличия воспаления в организме), важно правильно сдать анализ крови. На СОЭ влияет довольно много факторов, так что при сдаче анализа рекомендуется проводить его натощак и в спокойном состоянии.
- Не следует сдавать кровь после рентген-обследования, приема пищи, долгого плача или физиотерапии.
- Желательно, чтобы ребенок ел до забора крови не позже, чем за 8 часов.
- Кроме того, за два дня до обследования из детского рациона следует исключить очень калорийную и жирную пищу.
- В день перед анализом ребенку не следует давать жареные или копченые блюда.
- Непосредственно перед забором крови малыша нужно успокоить, ведь капризы и переживания провоцируют повышение СОЭ.
- Не рекомендуется приходить в поликлинику и сразу сдавать кровь – лучше, чтобы ребенок некоторое время отдохнул после улицы в коридоре и был спокоен.
Рекомендуем посмотреть выпуск программы Доктора Комаровского, в котором подробно освещается тема клинического анализа крови у детей
Общий анализ крови у детей: особенности проведения и расшифровка результатов
Содержание в крови специфических белков может указывать на наличие того или иного заболевания.
Глюкоза является одним из центральных метаболитов обменных процессов в организме. Отклонение от нормы ее содержания в крови представляет угрозу не только здоровью, но и жизни человека.
Некоторые медицинские центры предлагают бесплатные консультации специалиста по оказываемым услугам.
Для того чтобы результаты анализов были максимально достоверными, необходимо правильно подготовиться к их сдаче.
Получите необходимые медицинские услуги не выходя из дома.
Сэкономьте на медицинском обследовании, став участником специальной дисконтной программы.
Контроль качества клинических лабораторных исследований, осуществляемый по международным стандартам, – весомый аргумент при выборе лаборатории.
Общий анализ крови (сокращенно ОАК), пожалуй, самый распространенный вид лабораторной диагностики, который дает возможность сделать первые выводы о состоянии больного. В педиатрии это исследование играет особую роль, ведь маленькие пациенты часто попросту не могут подробно рассказать о своих жалобах. Несколько миллилитров крови, взятой из пальца, позволяют подтвердить подозрение на инфекцию или, напротив, исключить некоторые предположения о возможных причинах болезни ребенка. А повторный анализ крови является надежным способом оценить эффективность лечения малыша.
Нормальные показатели
Когда проводится расшифровка анализа крови, все показатели сравнивают с нормативами, которые зависят от возраста детей. Это относится и к скорости оседания красных кровяных клеток, ведь СОЭ сразу после рождения будет одной, в возрасте 2-3 года или 8-9 лет показатель будет другим.
Нормой СОЭ являются такие результаты:
Отклонения СОЭ от нормы зачастую проявляются повышением этого показателя, а снижение скорости, с которой оседают эритроциты, наблюдается намного реже. Наиболее частой причиной таких изменений выступает повышенная вязкость крови.
Более низкая СОЭ бывает при:
- Обезвоживании, например, вследствие острой кишечной инфекции.
- Пороках сердца.
- Серповидной анемии.
- Ацидозе (понижении рН крови).
- Тяжелом отравлении.
- Резком уменьшении веса.
- Приеме стероидных медикаментов.
- Повышении количества клеток крови (полицитемии).
- Присутствии в крови эритроцитов с измененной формой (сфероцитоз или анизоцитоз).
- Патологиях печени и желчного пузыря, особенно проявляющихся гипербилирубинемией.
Общая информация
Пониженное значение
Если показатель СОЭ ниже нормы, то причинами могут быть:
- Патология системы крови (нарушение свертывания вследствие врожденного или приобретенного дефицита факторов свертывания, анемия).
- Острые и хронические интоксикации. Скорость оседания эритроцитов нередко снижается, когда дети употребляют системные медикаментозные средства без ведома родителей.
- Дегидратация (обезвоживание). Причинами могут быть усиленное выведение жидкости из организма в результате большой физической активности, сильной потливости, холеры, острых кишечных инфекций (дизентерии, сальмонеллеза) и недостаточное потребление жидкости.
- Истощение. Причина — недостаточное питание (недостаток белков, жиров и углеводов).
- Вирусный гепатит.
- Сердечная патология.
- Эпилепсия.
- Многократная рвота.
- Острая диарея.
- Нехватка в рационе минеральных веществ и витаминов.
- Вегетарианство. Способствует острой нехватке в организме железа, которое входит в состав гемоглобина эритроцитов.
Падение СОЭ в 3 года и старше в некоторых случаях обусловлено легочной патологией и миеломной болезнью. Если скорость оседания красных клеток крови уменьшается, то это значит, что у ребенка имеются врожденные пороки развития сердца.
Чем отличается этот метод от других?
Кроме СОЭ по Вестергрену у нас в стране широко распространена методика Панченкова. Для этого в специальный капилляр помещают реактив (пятипроцентный натрий лимоннокислый), разведенный цельной кровью. Спустя шестьдесят минут измеряют высоту отстоявшейся плазмы.
Показатели СОЭ по методу Вестергрена и Панченкова при нормальных значениях одинаковы. Но при ускорении оседания эритроцитов данные по первой методике отражаются более высокими цифрами.
Существует также метод Винтроба. Он считается менее точным, чем два первых, поэтому его используют редко. В модернизированных лабораториях часто применяют автоматические анализаторы, которые выдают и результат СОЭ в том числе.
Причины повышения СОЭ
Высокая СОЭ у ребенка не всегда свидетельствует о проблемах со здоровьем. Такой показатель может меняться под влиянием разных факторов, иногда безвредных или временно действующих на ребенка. Однако довольно часто увеличение СОЭ выступает признаком болезни, и иногда весьма серьезной.
Неопасные
При таких причинах характерно незначительное повышение СОЭ, например, до 20-25 мм/ч. Такой показатель СОЭ может выявляться:
- При прорезывании зубов.
- При гиповитаминозе.
- Если ребенок принимает ретинол (витамин А).
- При сильных переживаниях или стрессе, например, после длительного плача малыша.
- При строгой диете или голодании.
- При приеме некоторых лекарств, например, парацетамола.
- При ожирении.
- При избытке жирной пищи в рационе крохи или кормящей мамы.
- После вакцинации от гепатита В.
Кроме того, в детском возрасте может выявляться так называемый Синдром повышенного СОЭ. При нем показатель высокий, но у ребенка нет каких-либо жалоб и проблем со здоровьем.
Патологические
При заболеваниях СОЭ повышается намного больше нормы, например, до 45-50 мм/ч и выше. Одной из главных причин более быстрого оседания эритроцитов выступает увеличение количества белка в крови за счет повышения уровня фибриногена и выработки иммуноглобулинов. Это состояние возникает в острую фазу многих заболеваний.
Увеличение СОЭ наблюдают при:
- Инфекционных заболеваниях. Повышенный показатель нередко диагностируют при бронхите, ОРВИ, скарлатине, гайморите, краснухе, цистите, пневмонии, паротите, а также при туберкулезе и других инфекциях.
- Отравлениях, например, вызванных токсинами в пище или солями тяжелых металлов.
- Гельминтозах и лямблиозе.
- Анемии или гемоглобинопатии.
- Травмах как мягких тканей, так и костей. Также СОЭ повышается в период восстановления после операции.
- Аллергических реакциях. СОЭ повышается и при диатезе, и при анафилактическом шоке.
- Заболеваниях суставов.
- Опухолевых процессах, например, при лейкозе или лимфоме.
- Эндокринных патологиях, к примеру, при сахарном диабете или тиреотоксикозе.
- Аутоиммунных болезнях, в частности, при волчанке.
Норма СОЭ у деток разного возраста в таблице
СОЭ у детей зависит от того, сколько лет ребенку. Следует учитывать, что уровень СОЭ у подростка также зависит от его половой принадлежности. Незначительные отклонения от нормы часто свидетельствуют о неправильном питании, стрессе или легком простудном заболевании. В общем случае считается, что чем сильнее отклонение и выше скорость оседания эритроцитов, тем серьезнее болезнь.
В различных источниках предлагаются разные предельные значения нормальных показателей СОЭ у малышей, диапазон может становится шире по мере взросления. Норма СОЭ для малышей с рождения до достижения подросткового возраста приведена в таблице ниже. Следует помнить о том, что организм каждого ребенка индивидуален, и окончательные выводы об отклонениях значения делает только доктор.
К примеру, если СОЭ у ребенка 2 лет равна 10, это нормально. Если же по результатам анализов значение скорости оседания эритроцитов составило 20 – есть повод сдать анализы повторно и пройти комплексное обследование для выявления патологических или физиологических причин такого значительного отклонения от нормы.
Как понизить уровень
Повышенное СОЭ в крови у ребенка говорит о соматической (чаще всего инфекционной) патологии. Все причины ускорения СОЭ можно условно разделить на опасные и неопасные, инфекционные (бактериальные, вирусные, грибковые, глистные, протозоозные), неинфекционные, органические и функциональные.
Предлагаем ознакомиться Аевит для лица против морщин до и после
Неопасные причины
Если СОЭ повышена до 19-21 мм/час, то причинами могут быть:
- Острые респираторные заболевания (аденовирусная и риновирусная инфекции, грипп, ОРВИ, парагрипп). При своевременном лечении они не представляют опасности для ребенка. СОЭ в течение нескольких дней может быть на высоком уровне после болезни, когда симптомы заболевания уже отсутствуют.
- Нетяжелые аллергические реакции. У таких детей наряду с повышением скорости оседания эритроцитов повышается содержание в крови эозинофилов и имеются положительные аллергические пробы. В качестве аллергенов могут выступать медикаменты, пыльца, неадаптированные смеси, продукты питания, пищевые добавки и другие вещества.
- Прорезывание зубов. Наряду с увеличением СОЭ нередко у ребенка повышается температура.
- Применение лекарств на основе парацетамола.
Причины повышения СОЭ могут крыться в снижении иммунитета, недавно проведенной вакцинации, избыточном весе (ожирении) и кормлении грудным молоком с высоким содержанием липидов.
Если СОЭ у ребенка повышена до 22-25 мм/час и держится на этом уровне длительное время, то требуется комплексное обследование. СОЭ 30-35 мм/час и более может означать наличие следующей патологии:
- Ювенильного ревматоидного артрита. Заболевание дебютирует чаще всего у детей младше 16 лет и характеризуется воспалением суставов (чаще двух и более), а также внесуставными симптомами (увеличением лимфатических узлов, поражением сердца, почек, печени и глаз). Повышение СОЭ выявляется в периоды обострения заболевания. Дополнительно выявляются признаки артрита, ревматоидный фактор и наличие антинуклеарных антител.
- Аутоиммунной патологии (системной красной волчанки, ревматизма).
- Заболеваний крови (лейкоза, гемобластозов). Лейкоз — это онкологическая патология крови, характеризующаяся нарушением процесса кроветворения и заменой зрелых клеток бластными. У детей чаще диагностируется острая форма. Повышенное СОЭ у ребенка сочетается со снижением тромбоцитов, падением гемоглобина и снижением уровня эритроцитов. Клинически заболевание проявляется бледностью кожи, повышением температуры, болью в мышцах, кровоточивостью, поражением слизистых и симптомами поражения сердца.
- Заболеваний почек и печени (гепатита, гломерулонефрита, пиелонефрита, амилоидоза).
- Дисфункции щитовидной железы. СОЭ 26-28 мм/час нередко выявляется при гипотиреозе и гипертиреозе. Причина — нарушение выработки тиреоидных гормонов (трийодтиронина и тироксина), участвующих в обменных процессах.
- Сахарного диабета.
- Заболеваний соединительной ткани (дерматомиозита, склеродермии).
- Туберкулеза. Характеризуется специфическим воспалением легочной ткани. Повышение СОЭ до 23-27 мм/час вызывают микобактерии туберкулеза.
- Травм.
- Пневмонии. При воспалении легких СОЭ может достигать 29-31 мм/час, а при двустороннем поражении этот показатель еще выше. Ценными диагностическими признаками являются симптомы интоксикации, затруднение дыхания, кашель с мокротой, боль в груди и затемнение легких на рентгенограмме.
- Других бронхо-легочных заболеваний (астмы, бронхита, трахеобронхита).
- Сепсиса. Нередко он развивается у новорожденных. При сепсисе микробы вместе с токсинами устремляются в кровоток и распространяются по организму, что приводит к повышению СОЭ до 50 мм/час и более.
- Инфаркта внутренних органов (почек, селезенки, сердца).
- Гельминтозов (аскаридоза, энтеробиоза, трихоцефалеза, описторхоза, дифиллоботриоза).
- Острых инфекционных заболеваний (ротавирусной инфекции, ангины, коклюша, паротита, кори, краснухи, коклюша, скарлатины). При ротавирусной инфекции высокое значение СОЭ сопровождается слабостью, лихорадкой, симптомами гастроэнтерита (тошнотой болью в животе, диареей, вздутием, рвотой) и судорогами. Отмечается зимне-весенняя сезонность. При скарлатине СОЭ часто повышается до 32-34 мм/час. Наблюдаются покраснение миндалин, боль при глотании, увеличение шейных лимфатических узлов и симптомы интоксикации.
- Злокачественных новообразований (рака). На поздних стадиях показатели СОЭ могут превышать 46-56 мм/час. Причина — сильная интоксикация организма продуктами распада опухоли. Клинически заболевание проявляется симптомами дисфункции пораженных органов, кахексией (потерей веса), недомоганием и слабостью.
Предлагаем ознакомиться Диета при атопическом дерматите у детей таблица
Если в ходе анализа выявлен высокий уровень СОЭ, то проводятся дополнительные исследования. Могут потребоваться:
- биохимический анализ;
- исследование крови на онкомаркеры;
- УЗИ;
- рентгенография;
- КТ и МРТ;
- электрокардиография;
- сцинтиграфия;
- биопсия с цитологическим исследованием;
- осмотр слизистых;
- коагулограмма;
- специфические исследования (серодиагностика, вирусологические анализы).
Если ускорение СОЭ до 37-38 мм/час обусловлено инфекцией, то могут назначаться:
- антибиотики (пенициллины, цефалоспорины, макролиды, фторхинолоны, карбапенемы);
- противовирусные средства;
- противогрибковые препараты;
- противоглистные средства (Немозол, Вермокс, Пирантел);
- жаропонижающие препараты.
При системной патологии назначаются кортикостероиды (Преднизолон). При СОЭ 39-58 мм/час на фоне сепсиса требуются вскрытие гнойных очагов, дезинтоксикационная терапия (инфузии), инъекционное введение антибиотиков и очищение крови. В случае развития лейкоза показаны полихимиотерапия и иммунотерапия. При гриппе и ОРВИ показаны противовирусные препараты и иммуностимуляторы (Тамифлю, Ингавирин, Амиксин, Кагоцел, Трекрезан или Эргоферон). Все лекарства назначаются с учетом возраста больного ребенка, переносимости и противопоказаний.
Суть диагностической методики
Диагностическая проба базируется на действии гравитации на форменные элементы крови — эритроциты. В лабораторных условиях в крови, лишённой способности свёртываться, красные кровяные тельца постепенно оседают в нижнюю часть пробирки. Именно скорость этого процесса и имеет диагностическое значение.
К моменту завершения периода времени, отведённого на диагностическую пробу (1 час), на дне лабораторной посуды образуется густой неоднородный осадок из осевших эритроцитов, имеющий тёмно-бордовый оттенок. В пробирке же остаётся светлая полупрозрачная жидкость — плазма крови.
Скорость процесса оседания кровяных телец напрямую зависит от их способности к агрегации: чем лучше они слипаются друг с другом, тем меньше их сопротивление в жидкой среде, следовательно, и скорость оседания в нижнюю часть пробирки под действием силы тяжести.
На этот процесс, помимо свойств самих эритроцитов, влияют также и другие органические соединения, входящие в состав крови:
Указанные вещества, воздействуя на заряд поверхности эритроцитов, способны повышать их способность к агрегации, что увеличивает скорость их оседания. Определение скорости оседания эритроцитов происходит в течение часа и измеряется в миллиметрах в час.
Именно такой способ регистрация СОЭ при помощи специальных пробирок, имеющих просвет 2,4 — 2,5 мм стал общепринятым, поскольку имеет более выраженную чувствительность по отношению к повышению скорости оседания кровяных телец, а значит, помогает диагностировать даже самые слабовыраженные нарушения.
Обязательным условием корректного проведения диагностической пробы является блокирование способности крови к свёртыванию. В качестве консерванта, позволяющего биологическому материалу оставаться в жидком состоянии, традиционно используется цитрат натрия с концентрацией 3,8%. Для лабораторного теста венозная кровь берётся с цитратом натрия в соотношении четыре к одному.
Автор, описавший и впервые начавший применять эту методику — Вестергрен (Westergren). В честь него и названа диагностическая проба — метод Вестергрена.
Альтернативным способом измерения этого параметра является методика Панченкова, которую нередко сравнивают с измерением СОЭ по Вестергрену. Описания их действительно весьма схожи. Отличие заключается в том, что Панченков использовал вместо пробирки капиллярную трубку с градуировкой, которая показывает высоту, и штатив с гнездом для ее установки.
Для стабилизации крови при анализе по этому методу используется пятипроцентный раствор цитрата натрия, с которым смешивается капиллярная кровь перед тем, как заполнить ею капилляр и поставить на штатив. Результат диагностической пробы оценивается через час путём измерения высоты столба плазмы в капиллярной трубке.
СОЭ при инфекциях
Наиболее частой патологической причиной увеличения СОЭ выступают инфекционные болезни. При этом определить характер
инфекции
можно по лейкоцитарной формуле, ведь лейкоциты и СОЭ повышены у ребенка и при вирусной, и при бактериальной инфекции. Однако в случае заражения вирусом в лейкоформуле будет лимфоцитоз. Если же инфекция бактериальная, подсчет лейкоцитов отметит увеличенное число нейтрофилов.
О норме СОЭ и причинах повышенных показателей смотрите в следующем видео.
Симптомы
В некоторых случаях ребенка вообще ничего не беспокоит, а изменение СОЭ выявляется при плановом обследовании. Однако нередко высокая СОЭ является признаком болезни, поэтому у малышей будет и другая симптоматика:
- Если эритроциты оседают быстрее из-за сахарного диабета, у ребенка будет отмечаться повышенная жажда, учащение мочеиспусканий, снижение массы тела, возникновение кожных инфекций, молочницы и другие признаки.
- При повышении СОЭ из-за туберкулеза ребенок будет терять вес, жаловаться на недомогание, кашель, боли в груди, головные боли. Родители заметят у него небольшое повышение температуры и ухудшенный аппетит.
- При такой опасной причине повышения СОЭ, как онкопроцесс, у малыша снизится иммунитет, увеличатся лимфоузлы, появится слабость, уменьшится вес.
- Инфекционные процессы, при которых СОЭ повышается чаще всего, будут проявляться резким подъемом температуры, учащением сердцебиений, одышкой и другими признаками интоксикации.
Что делать
Так как наиболее часто высокая СОЭ сигнализирует врачу о наличии в организме ребенка воспалительного процесса, изменение такого показателя не должно оставаться без внимания педиатра. При этом действия медиков определяются наличием у ребенка каких-либо жалоб.
Если каких-либо проявлений болезни у ребенка нет, а СОЭ в анализе крови высокая, врач направит ребенка на дополнительное обследование, которое будет включать биохимический и иммунологический анализ крови, рентген грудной клетки, анализ мочи, ЭКГ и другие методы.
Если никаких патологий выявлено не будет, а повышенное СОЭ, например, 28 мм/ч, будет оставаться единственным настораживающим симптомом, педиатр через некоторое время направит малыша на пересдачу клинического анализа крови. Также ребенку порекомендуют определить С-реактивный белок в крови, по которому судят об активности воспаления в организме.
Если увеличение СОЭ выступает симптомом какого-либо заболевания, педиатр назначит медикаментозное лечение. Как только ребенок выздоровеет, показатель вернется к нормальным значениям. При инфекционной болезни ребенку назначат антибиотики и другие лекарства, при аллергии малышу выпишут антигистаминные препараты.
Какое требуется лечение?
Когда индекс скорости оседания красных клеток незначительно превышает норму, состояние ребенка стабильное, беспокоиться нет причин. Для собственного комфорта через небольшой промежуток времени можно повторно сдать анализы и убедиться, что малышу ничего не угрожает.
Если параметры СОЭ превышают отметку в 15 мм/ч, практически всегда это означает наличие инфекционного очага в организме. Когда этот показатель доходит примерно до 30-40 мм/ч, это явный признак серьезного заболевания, борьба с которым может занять несколько месяцев.
Повышенный СОЭ у ребенка всегда означает нарушение в работе организма. Педиатру в первую очередь необходимо определить первопричину, которая спровоцировала такие изменения. Для этого может потребоваться более серьезное обследование. После врач должен назначить лечение конкретного заболевания. Обычно оно подразумевает прием антибиотиков и противовирусных средств.